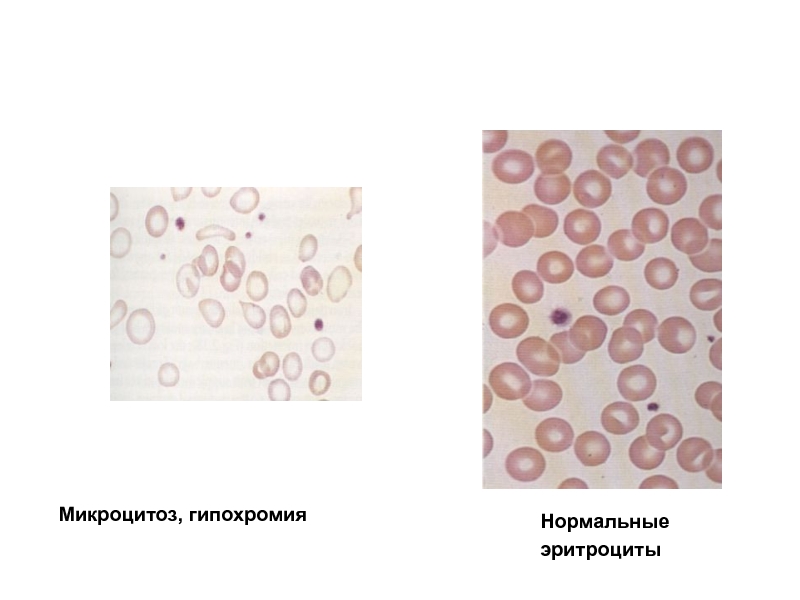
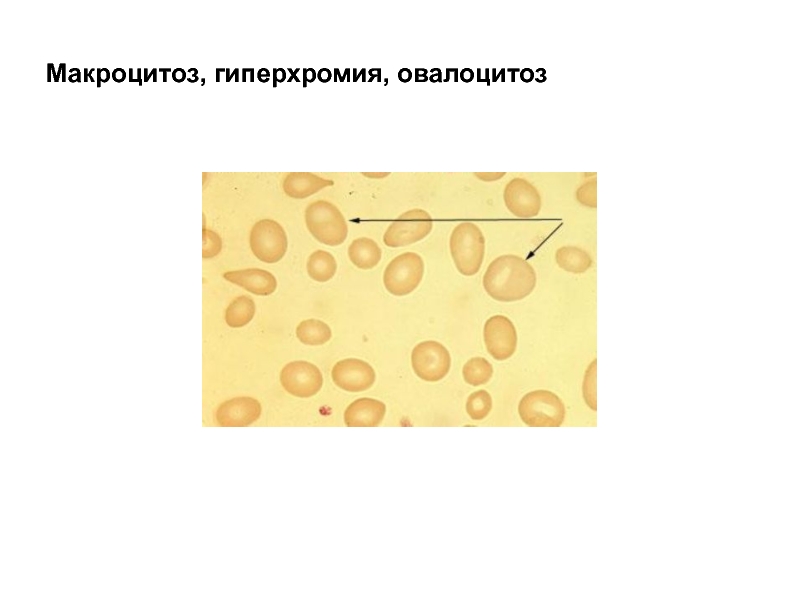

Разделы презентаций
- Разное
- Английский язык
- Астрономия
- Алгебра
- Биология
- География
- Геометрия
- Детские презентации
- Информатика
- История
- Литература
- Математика
- Медицина
- Менеджмент
- Музыка
- МХК
- Немецкий язык
- ОБЖ
- Обществознание
- Окружающий мир
- Педагогика
- Русский язык
- Технология
- Физика
- Философия
- Химия
- Шаблоны, картинки для презентаций
- Экология
- Экономика
- Юриспруденция
Железодефицитные, витамин В 12 - и фолиеводефицитные анемии 4 курс профессор
Содержание
- 1. Железодефицитные, витамин В 12 - и фолиеводефицитные анемии 4 курс профессор
- 2. Анемия – снижение числа эритроцитов или уровня
- 3. Диагностическиe критерии анемииДля взрослых мужчин - Нв
- 4. Международные критерии диагноза анемии (Guideline-anaemia, Nethrol Dial
- 5. Относительное перераспределение жидкости в организме влияет на оценку количества эритроцитов, содержание гемоглобина и гематокрита в крови.
- 6. Относительное увеличение объема плазмы (гематокрит диспропорционально низкий)увеличение
- 7. Нормальная гомеостатическая реакция организма на анемию –
- 8. Ретикулоцитарный пролиферативный индекс (RPI)RPI < 2 нарушение
- 9. Кинетическая классификация анемий (G.R.Lee,1999). Анемии, связанные с нарушением продукции эритроцитов (RPI
- 10. Кинетическая классификация анемий (продолжение)II. Анемии с повышенной
- 11. Морфологическая классификация анемийНа основании оценки размеров эритроцитов
- 12. Макроцитарные анемии – мегалобластные немегалобластные
- 13. Этиопатогенетическая классификация мегалобластных анемий (1)I.Дефицит витамина В12
- 14. Этиопатогенетическая классификация мегалобластных анемий (2)Д. Семейная избирательная
- 15. Этиопатогенетическая классификация мегалобластных анемий (3)2.Дефицит фолиевой кислотыА.
- 16. Этиопатогенетическая классификация мегалобластных анемий (4)4. Врожденные заболевания,
- 17. Этиопатогенетическая классификация мегалобластных анемий (5)5. Лекарство- и
- 18. Немегалобластные макроцитарные анемии1. Заболевания сопровождающиеся повышенным эритропоэзомА.
- 19. Этиопатогенетическая классификация микроцитарных и гипохромных анемий (1)Анемии,
- 20. Этиопатогенетическая классификация микроцитарных и гипохромных анемий (2)2.
- 21. Этиопатогенетическая классификация нормоцитарной нормохромной анемии 1.1. Анемия,
- 22. Этиопатогенетическая классификация нормоцитарной нормохромной анемии 2Б. Анемия,
- 23. Степени тяжести анемииЛегкая – Hb > 90
- 24. Показатели красной крови в норме3 - 253
- 25. Алгоритм диагностики анемииКлинический анализ крови. Морфологический анализ
- 26. Микроцитоз, гипохромияНормальные эритроциты
- 27. Цветовой показатель = Hb г/л х 3
- 28. Определение морфологического варианта анемииГиперхромнаяMCH > 34 пгMCHC
- 29. Алгоритм диагностики микроцитарных гипохромных анемийГипохромная и/или микроцитарная
- 30. Алгоритм диагностики нормоцитарных нормохромных анемийКоличество ретикулоцитов в
- 31. Алгоритм диагностики макроцитарных анемийМорфология крови и костного
- 32. Железодефицитная анемия – клинико-гематологический синдром, характеризующийся нарушением
- 33. Распространенность железодефицитной анемии По данным ВОЗ железодефицитная анемия
- 34. Основные причины развития железодефицитных состоянийПотери железа, обусловленные
- 35. Потребности в железе мужчин и женщин в различном возрасте
- 36. Слайд 36
- 37. Слайд 37
- 38. Слайд 38
- 39. Стадии развития дефицита железа в организме Прелатентный дефицит железаЛатентный дефицит железаЖДА
- 40. 85%>69%NNЖелезосвязывающая способность↓N or ↓NNNMCV
- 41. Диагностика железодефицитной анемии63% больных ЖДА имеют симптомы
- 42. Клинические проявления ЖДА Анемический синдромСидеропенический синдром
- 43. Анемический синдромСлабость, снижение толерантности к физическим нагрузкамБледность
- 44. Сидеропения (гипосидероз)Органы-мишени при сидеропении:Кожа, придатки кожи, слизистыеЖелудочно-кишечный трактНервная системаСердечно-сосудистая системаМышечная ткань
- 45. Симптомы сидеропении у больных железодефицитной анемией (1)Общая
- 46. Симптомы сидеропении у больных железодефицитной анемией (2) Ломкость,
- 47. Железодефицитная анемияБледность, тусклость ногтевого ложа у пациента со смуглой кожей
- 48. Железодефицитная анемия. КойлонихииВогнутые, истонченные, ломкие
- 49. Симптомы сидеропении у больных железодефицитной анемией (3)Извращение
- 50. Железодефицитная анемия.
- 51. Железодефицитная анемия
- 52. Атрофия и сглаженность сосочков на языке у больного железодефицитной анемией
- 53. Симптомы сидеропении у больных железодефицитной анемией (4)Сидеропеническая
- 54. Синдром сидеропенической дисфагии (синдром Пламмера-Винсона)Атрофия слизистой полости
- 55. Симптомы сидеропении у больных железодефицитной анемией (5) Специфическая
- 56. Бледность кожных покровов и слизистых у больных
- 57. Симптомы сидеропении у больных железодефицитной анемией (6)Зябкость,
- 58. Симптомы сидеропении у больных железодефицитной анемией (7) Повышенная
- 59. Железодефицитная анемияМножественные ретинальные кровоизлияния у 25-летней женщины с тяжелой железодефицит-ной анемией на фоне обильных меноррагий
- 60. Слайд 60
- 61. Особенности клинических проявлений ЖДА у пожилых больныхАдаптация
- 62. Железодефицитная анемияКровоточащая язва 12-перстной кишки, выявленная эндоскопией
- 63. Железодефицитная анемияАденокарцинома толстого кишечника как причина железодефицитной анемии
- 64. Лабораторные признаки железодефицитной анемииНизкий цветовой показатель (
- 65. Железодефицитная анемия. Морфология кровиЖДА. Микроцитоз, гипохромия, пойкилоцитознорма
- 66. Железодефицитная анемия Морфология костного мозгаМикронормобластический эритропоэз. Цитоплазма эритробластов скудная, вакуолизированная и нерегулярная, отсутствие сидеробластов
- 67. Принципы лечения железодефицитной анемииУстранение причины анемииЗаместительная терапия
- 68. Необходимая суточная доза элементарного железа для лечения
- 69. Препараты железа для лечения ЖДАЖелеза сульфат +
- 70. Препараты железа для лечения ЖДА (2)Железа фумаратХеферол,
- 71. Парентерально препараты железа могут применяться при следующих
- 72. Комплексные препараты железа для лечения ЖДАФерретаб (железа
- 73. Оценка эффективности терапии ЖДАПервые дни лечения –
- 74. В12-дефицитная анемияПервое описание Combe and Andral в
- 75. Основные этапы метаболизма витамина B12Витамин В12 (кобаламин)
- 76. Наиболее частые причины В12-дефицитных анемийДефицит пищевой Недостаток
- 77. Изменения слизистой желудка при пернициозной анемии
- 78. Пернициозная анемия. Антитела к париетальным клеткам желудка
- 79. Пернициозная анемияГолубые глазаРанняя сединаВитилигоГипер- гипотиреозСахарный диабет
- 80. Клинические проявления B12-дефицитной анемииСимптомы анемии и поражения
- 81. Мегалобластная анемияГлоссит –увеличенный малиновый язык, лакированный язык, болезненный, чувствительный к горячему и кисломуАнгулярный хеилит
- 82. Неврологические проявления при В12-дефицитной анемииПовышенные рефлексы,
- 83. Лабораторные признаки В12-дефицитной анемииМакроцитарная анемия (средний объем
- 84. Макроцитоз, гиперхромия, овалоцитоз
- 85. Картина крови и костного мозга у больных В12-дефицитной анемией
- 86. Лечение В12-дефицитной анемииУстранение причины (если возможно)Цианкобаламин или
- 87. Причины фолиеводефицитной анемии Пищевой дефицит (суточная потребность 25-100
- 88. Клиническая симптоматика фолиеводефицитной анемииКлинические проявления как при
- 89. Фолиеводефицитная анемияСпонтанные кровоизлияния в кожу у больной
- 90. Лечение фолиеводефицитной анемии Фолиевая кислота 1-5 мг/сутки per
- 91. Скачать презентанцию
Слайды и текст этой презентации
Слайд 2Анемия – снижение числа эритроцитов или уровня гемоглобина в крови
из-за кровопотери, нарушения продукции, повышенного разрушения или их сочетания.
Слайд 3Диагностическиe критерии анемии
Для взрослых мужчин - Нв < 130 г/л,
эритроциты < 4,0х 1012/л,
Для взрослых женщин - Нв
г/л, эритроциты < 3,5 х1012/лСлайд 4Международные критерии диагноза анемии (Guideline-anaemia, Nethrol Dial Transplant, 1999, s.5.,5.
Hb
< 11 г/дл (Ht < 33%) у женщин до менопаузы
Hb
< 12 г/дл (Ht < 37%) у взрослых мужчин и женщин после менопаузыСлайд 5 Относительное перераспределение жидкости в организме влияет на оценку количества эритроцитов,
содержание гемоглобина и гематокрита в крови.
Слайд 6Относительное увеличение объема плазмы (гематокрит диспропорционально низкий)
увеличение жидкости в организме
во время беременности
увеличение жидкости в организме на фоне олигурии при
почечной недостаточности и при выраженной сердечной недостаточностихронические заболевания, гипоальбуминемия
длительное пребывание в положении лежа
спленомегалия
Слайд 7Нормальная гомеостатическая реакция организма на анемию – активация эритропоэза. Если
система обратной связи функционирует нормально, то степень активации эритроидного ростка
гемопоэза прямо пропорциональна тяжести анемии.Повышенную продукцию эритроидных клеток отражает увеличение в крови циркулирующих ретикулоцитов. Ретикулоцитарный пролиферативный индекс (RPI) рассчитывается по гематологическим данным.
Кинетическая классификация анемий основана на оценке реактивности гемопоэза на снижение числа циркулирующих эритроцитов и изменению RPI.
Слайд 8Ретикулоцитарный пролиферативный индекс (RPI)
RPI < 2
нарушение продукции эритроцитов
RPI
> 3
увеличение продукции эритроцитов
RPI= ретикулоциты (%) / время созревания
ретикулоцитов (дни) х гематокрит 0,45Время созревания 1 день при гематокрите 0,45, 1,5 дня при 0,35,
2 дня – при 0,25, 2,5 дня при 0,15.
Пример:
У больного Ht = 0,25, Количество ретикулоцитов в крови = 20%.
Время созревания ретикулоцитов – 2 дня.
RPI = 20/2,0 x 0,25
0,45 = 5,5
Слайд 9Кинетическая классификация анемий (G.R.Lee,1999).
Анемии, связанные с нарушением продукции эритроцитов (RPI
б).Нарушение эритропоэза, связанное со снижением продукции эритропоэтина
Заболевания почек
Гормональная недостаточность
в).Гипопластическая анемия
Апластическая анемия
Парциальная красноклеточная аплазия
г).Нарушение эритропоэза, связанное с инфильтрацией костного мозга
Лейкоз
Опухоль
Миелофиброз
2). Анемии, обусловленные неэффективным эритропоэзом
а) Мегалобластные
В12-дефицитные
Фолиеводефицитные
Смешанные
б) Микроцитарные
Талассемия
Сидеробластные анемии
в). Нормоцитарные анемии
Слайд 10Кинетическая классификация анемий (продолжение)
II. Анемии с повышенной продукцией эритроцитов (RPI>3)
1).
Гемолитические анемии
а) врожденные
б) приобретенные
2) Анемии на фоне полного парентерального питания
3)
Постгеморрагические анемии ? (ранний период после массивного кровотечения)Слайд 11Морфологическая классификация анемий
На основании оценки размеров эритроцитов (объема, диаметра, площади,
толщины клетки), внутриклеточного содержания гемоглобина, построении кривой распределения эритроцитов по
их объему все анемии делятся намакроцитарные
(средний объем эритроцитов >100 мкм3)
нормоцитарные
(средний объем эритроцитов 80-100 мкм3),
микроцитарные
(средний объем эритроцитов <80 мкм3).
Слайд 13Этиопатогенетическая классификация мегалобластных анемий (1)
I.Дефицит витамина В12
А. Дефицит пищевой
( редко)
Б. Недостаток или отсутствие внутреннего фактора Кастла
1). Пернициозная анемия
а) врожденная формаб) взрослая форма
2) Операции на желудке а) полная резекция желудка
б) частичная резекция желудка
в) обходной анастомоз
3) Прием с пищей ядов и химически активных веществ
В. Нарушение функции внутреннего фактора
Г. Биологическая конкуренция
1). Бактериальная перегрузка тонкого кишечника
а) дивертикулы кишечника
б) анастомозы и фистулы
в) перекрут
г) стриктуры
д)склеродермия
е) ахлоргедрия
2) Ленточный червь
Слайд 14Этиопатогенетическая классификация мегалобластных анемий (2)
Д. Семейная избирательная витамин В12 малоабсорбция
Е.
Лекарственно-обусловленная витамин В12 малоабсорбция
Ж. Хронические заболевания поджелудочной железы
З. Синдром Золлингера-Эллисона
И.
ГемодиализК. Заболевания подвздошной кишки
1) Резекция и обходной анастомоз
2) Региональный энтерит
Слайд 15Этиопатогенетическая классификация мегалобластных анемий (3)
2.Дефицит фолиевой кислоты
А. Пищевой дефицит
Б. Повышенное
потребление
1) алкоголизм и цирроз
2) беременность
3) младенческий возраст
4) заболевания, связанные с
повышенной клеточной пролиферациейВ. Врожденная малоабсорбция фолиевой кислоты
Г. Лекарственно-индуцированный дефицит
Д. Обширная резекция кишечника
3. Комбинированный дефицит витамина В12 и фолиевой кислоты
А. Тропическое спру
Б. Муковисцедозная энтеропатия
Слайд 16
Этиопатогенетическая классификация мегалобластных анемий (4)
4. Врожденные заболевания, сопровождающиеся нарушением синтеза
ДНК
А. Оротовая ацидурия
Б. Синдром Lesch-Nyhan (дефицит гипоксантин-гуанин- фосфорибозилтрансферазы) В. Тиамин
чувствительная мегалобластная анемияГ. Дефицит энзимов, участвующих в метаболизме фолиевой кислоты
1) метил-тетра-гидро-фолат-трансферазы
2) формиминотрансферазы
3) дигидрофолатредуктазы
Д. Дефицит транскоболамина II
E. Аномалии транскоболамина II
Ж. Гомоцистеинурия и метилмалоновая ацидурия
Слайд 17Этиопатогенетическая классификация мегалобластных анемий (5)
5. Лекарство- и токсининдуцированное нарушение синтеза
ДНК
А. Антагонисты фолиевой кислоты (метотрексат)
Б. Антагонисты пуринов (6-меркаптопурин)
В. Антагонисты пиримидина
(цитозин-арабинозид)Г. Алкилирующие агенты (циклофосфамид)
Д. Зидовудин (ретровир)
Е. Триметоприм
Ж. Оральные контрацептивы
З. Противосудорожные (дилантин)
И. Окись азота
К. Мышьяк
6. Эритролейкемия
Слайд 18Немегалобластные макроцитарные анемии
1. Заболевания сопровождающиеся повышенным эритропоэзом
А. Гемолитические анемии
Б. Постгеморрагическая
анемия
2. Заболевания сопровождающиеся увеличением площади мембран (тонкие макроциты)
А. Заболевания печени
Б.
Механическая желтухаВ. Постспленэктомический синдром
3. Рефрактерные анемии
А. Миелодиспластический синдром
Б. Миелофтиз
В. Апластическая анемия
Г. Приобретенная сидеробластная анемия
Д. Врожденная дизэритропоэтическая анемия, тип1
Е. Идиопатический макроцитоз пожилых
Ж. Алкоголизм
З. Гипотиреоз
И. Хронические обструктивные заболевания легких
К. Доброкачественный семейный макроцитоз
Слайд 19Этиопатогенетическая классификация микроцитарных и гипохромных анемий (1)
Анемии, связанные с нарушением
метаболизма железа
А. Железодефицитная анемия
Б. Анемия хронических заболеваний
В. Атрансферинемия
Г. Врожденная гипохромная
микроцитарная анемия с перегрузкой железом (синдром Shahidi-Nathan-Diamond)Д. Семейная микроцитарная анемия со сниженными абсорбцией и метаболизмом железа
Е. Антитела к рецептору трансферина
Ж. Применение галлия
З. Интоксикация алюминием
И. Вторичный дефицит меди
Слайд 20Этиопатогенетическая классификация микроцитарных и гипохромных анемий (2)
2. Нарушение синтеза глобина
А.
Талассемии
Б. Гемоглобин Е
В. Гемоглобин С
Г. Нестабильный гемоглобин
3. Заболевания, сопровождающиеся нарушением
синтеза порфирина и гема4. Сидеробластные анемии
А. Нарушение синтеза аминолевуленовой кислоты
а) дефицит витамина В6
б) нарушение метаболизма витамина В6, обусловленное лекарствами и токсинами
Б. Дефицит копорфириногеноксидазы
В. Дефицит гемсинтетазы
Г. Интоксикация свинцом
Д. Идиопатическая (неясная этиология)
Слайд 21Этиопатогенетическая классификация нормоцитарной нормохромной анемии 1.
1. Анемия, ассоциированная с повышенной
продукцией эритроцитов
А. Постгеморрагическая анемия
Б. Гемолитическая анемия
2. Анемия, сопровождающаяся неадекватным ответом
костного мозгаА. Болезни системы кроветворения
1) Гипоплазии
а) гипо- и апластическая анемия
б) эритробластическая гипоплазия
2) Заболевания, характеризующиеся инфильтрацией костного мозга
а) лейкоз
б) миелома
в) миелофтиз
3) Дисэритропоэтические анемии
4) Миелодиспластические анемии
5) Маскирующаяся мегалобластная анемия
Слайд 22Этиопатогенетическая классификация нормоцитарной нормохромной анемии 2
Б. Анемия, связанная со снижением
продукции эритропоэтина
1). Поражение органов, продуцирующих эритропоэтин
2). Уменьшение стимуляции (снижение потребности
в кислороде) анемия эндокринной недостаточности3). Белковое и энергетическое голодание
4). Анемия хронических заболеваний
В. Дефицит железа на ранних стадиях
Г. Анемия космонавтов
Слайд 23Степени тяжести анемии
Легкая – Hb > 90 г/л
Средней степени тяжести
- Hb 70-90 г/л
Тяжелая Hb < 70 г/л
Слайд 24Показатели красной крови в норме
3 - 25
3 – 25
Фолиевая кислота
в сыворотке нг/мл
> 175
Витамин В12 в сыворотке пмоль/л
5 – 25
5
– 25Эритропоэтин, мЕд/мл
12 -20
12 – 18
Сывороточное железо, мкмоль/л
12 - 125
30– 300
Ферритин сыворотки, мкг/л
36 – 42
40 – 48
Гематокрит %
4,0 – 5,0
4,5 – 5,0
Количество эритроцитов, х 1012/л
120-160
130-180
Уровень гемоглобина, г/л
Женщины
Мужчины
Показатели красной крови
Слайд 25Алгоритм диагностики анемии
Клинический анализ крови. Морфологический анализ мазка крови. Расчет
эритроцитарных индексов.
Биохимические исследования
Морфологический анализ мазка костного мозга (миелограмма)
Гистологическое исследование костного
мозгаСпециальные лабораторные методы (электрофорез гемоглобина, определение ферментов эритроцитов и т.д.)
Инструментальные методы исследования
Слайд 27Цветовой показатель = Hb г/л х 3 (0,86-1,05)
3 цифры кол-ва
Эр
Средний корпускулярный объем эритроцитов (MCV)
MCV= Ht (%) x 10
(80-95 мкм3)кол-во Эр млн. в 1 мм3
Среднее содержание гемоглобина в эритроците (MCH) MCH = Hb г/л (25-34 пг/кл)
кол-во Эр х 1012/л
Средняя концентрация гемоглобина в эритроцитах (MCHC) (30-38г/дл)
MCHC = Hb г/л
Ht
Слайд 28Определение морфологического варианта анемии
Гиперхромная
MCH > 34 пг
MCHC > 38 г/дл
Нормохромная
MCH
= 24-34 пг
MCHC=30-38 г/дл
Гипохромная
MCH < 24 пг
MCHC < 30 г/дл
Макроцитарная
MCV
>100 мкм3Нормоцитарная
MCV= 80-99 мкм3
Микроцитарная
MCV <80 мкм3
Слайд 29Алгоритм диагностики микроцитарных гипохромных анемий
Гипохромная и/или микроцитарная анемия
Уровень сывороточного железа
Снижен
В норме Повышен
Ферритин Электрофорез Hb сидеробластов в к.м.
Снижен в
норме или Железо- Анемия Талассемия, Сидеробластная
дефицит- хронических гемоглобино- анемия
ная заболеваний патии
анемия
Слайд 30Алгоритм диагностики нормоцитарных нормохромных анемий
Количество ретикулоцитов в крови
Повышено Нормальное или
сниженное
Анамнез, клинические Скрининг для исключения Сывороточное
и инструментальные заболеваний эндокринной железо
данные,
уровень системы, почек и печени билирубина
Пост- Гемолити- Заболе- Заболе- Заболе- Негатив- Норма Снижено
геморраги- ческая вания вания вания ный или
ческая анемия печени почек эндокр. скрининг
анемия с-мы
Стернальная Анемия
пункция, трепанобиопсия смешанного
генеза, анемия хр. заб-ний
Апластическая МДС Инфильтрация Скрытая
анемия к.м. опухолевыми клетками В12-деф. анемия
Слайд 31Алгоритм диагностики макроцитарных анемий
Морфология крови и костного мозга
Мегалобластический Немегалопластический
эритропоэз эритропоэз
Определение уровня Количество ретикулоцитов
витамина В12 и фолиевой
кислоты в сыворотке крови
повышено в норме или ↓↓ витамина ↓ фолиевой ↓ вит. В12 норма Кровотечение алкоголизм
В12 к-ты ↓ фол. к-ты гемолиз б-ни печени
гипотиреоз
В12-деф. Фолиеводеф. муковисцедоз Насл. Лек. МДС
анемия анемия тропическое заб-я обусл. Апластич.
СПРУ анемия
Слайд 32Железодефицитная анемия – клинико-гематологический синдром, характеризующийся нарушением синтеза гемоглобина в
результате дефицита железа, развивающегося на фоне различных патологических и физиологических
процессов, и проявляющийся признаками анемии и сидеропенииСлайд 33Распространенность железодефицитной анемии
По данным ВОЗ железодефицитная анемия выявляется у 1788600000
жителей Земли
По данным ВОЗ скрытый дефицит железа имеет место у
3580000000 жителей ЗемлиСлайд 34Основные причины развития железодефицитных состояний
Потери железа, обусловленные кровотечением
- желудочно-кишечное кровотечение
(пептические язвы и множественные эрозии желудка, язвенный колит, опухоли, геморрой)
-
маточные кровотечения или обильные месячные- кровотечения носовые и другие
Алиментарная недостаточность
Нарушение усвоения (ахлоргидрия, резекция желудка, целиакия и др.)
Усиленное потребление
Слайд 39Стадии развития дефицита железа в организме
Прелатентный дефицит железа
Латентный дефицит железа
ЖДА
Слайд 4085%
>69%
N
N
Железосвязывающая способность
↓
N or ↓
N
N
N
MCV
г/дл
N
N
Свободный протопорфирин в Эр
≤10%
железа в костном мозгеПоздняя ЖДА
Ранняя ЖДА
Латентный
Прелатент-ный
N
Слайд 41Диагностика железодефицитной анемии
63% больных ЖДА имеют симптомы анемии
16% больных ЖДА
имеют симптомы заболеваний, лежащих в основе анемии
21% больных ЖДА не
предъявляют жалоб и диагноз установлен при лабораторном исследовании Слайд 43Анемический синдром
Слабость, снижение толерантности к физическим нагрузкам
Бледность кожных покровов и
слизистых
Головокружение
Шум в ушах
Мелькание мушек перед глазами
Сердцебиение
Одышка при физической нагрузке
Обморочные состояния,
гипотонияНарушения со стороны сердечно-сосудистой системы (сердечная недостаточность на фоне анемического сердца, ухудшение течения ИБС, дисциркуляторных энцефалопатий и т.д.)
Слайд 44Сидеропения (гипосидероз)
Органы-мишени при сидеропении:
Кожа, придатки кожи, слизистые
Желудочно-кишечный тракт
Нервная система
Сердечно-сосудистая система
Мышечная
ткань
Слайд 45Симптомы сидеропении у больных железодефицитной анемией (1)
Общая слабость, повышенная утомляемость,
снижение работоспособности и толерантности к физическим нагрузкам, невозможность сосредоточиться, снижение
памяти, длительный астенический синдром после перенесенных инфекцийСлайд 46Симптомы сидеропении у больных железодефицитной анемией (2)
Ломкость, слоистость ногтей, их
поперечная исчерченность, уплощение, тусклость, ложкообразная форма, невозможность отрастить длинные ногти
Расслаивание
кончиков волос, волосы секутся, невозможность отрастить длинные волосы Слайд 49Симптомы сидеропении у больных железодефицитной анемией (3)
Извращение вкуса, патофагия (желание
есть мел, пепел, землю и т.д)
Необычное пристрастие к запахам, патоосмия
(ацетон, бензин и т.д.)Сухость, истонченность, легкая травматизация кожи, нарушение целостности эпидермиса (ангулярный стоматит или заеды в углах рта)
Глоссит, сглаженность сосочков, трещины, чувство жжения языка
Слайд 53Симптомы сидеропении у больных железодефицитной анемией (4)
Сидеропеническая дисфагия (синдром Пламмера-Винсона),
нарушение глотания
Симптоматика гастрита (чувство тяжести, боли)
Дизурия и недержание мочи при
кашле, смехе, ночной энурезСлайд 54Синдром сидеропенической дисфагии (синдром Пламмера-Винсона)
Атрофия слизистой полости рта, глотки, пищевода
с дисфагией: расстройства глотания,чувство жжения в языке, спазм пищевода
Слайд 55Симптомы сидеропении у больных железодефицитной анемией (5)
Специфическая бледность кожи с
алебастровым ( у взрослых) или зеленоватым (у подростков) оттенком
Симптом голубых
склерСлайд 56Бледность кожных покровов и слизистых у больных железодефицитной анемией
69 летняя
женщина.
Гемоглобин 8,1 г/дл, Эритроциты 4,13 х 1012/л, ЦП =
0,6 гематокрит – 26,8%, Средний объем эритроцитов – 65 мкм3,
среднее содержание Hb в эритроците 19,6 рг.
Слайд 57Симптомы сидеропении у больных железодефицитной анемией (6)
Зябкость, холодные конечности
Невралгии (редко)
Вазоматорные
нарушения (редко)
Снижение чувствительности, ощущение скованности пальцев рук (редко)
Ощущение мурашек на
коже (редко)Возможно повышение внутричерепного давления, псевдоопухолевый синдром (редко у детей и подростков)
Слайд 58Симптомы сидеропении у больных железодефицитной анемией (7)
Повышенная склонность к инфекциям
Возможны
усиление меноррагий, появление кровоизлияний на глазном дне при тяжелой ЖДА
Слайд 59Железодефицитная анемия
Множественные ретинальные кровоизлияния у 25-летней женщины с тяжелой железодефицит-ной
анемией на фоне обильных меноррагий
Слайд 61Особенности клинических проявлений ЖДА у пожилых больных
Адаптация к низкому содержанию
гемоглобина
Малая выраженность проявлений гипосидероза в отношении кожи и слизистых
Множественность сопутствующей
патологии и симптомов (полиморбидность)Частое сочетание нескольких этиологических факторов,
Преобладание в клинике желудочно-кишечных расстройств (тошнота, тяжесть в эпигастрии, отсутствие аппетита, отрыжка, запоры и т.д.), мышечной слабости
Анемия – маска других заболеваний, например, ИБС
Сочетание нескольких анемий (ЖДА, анемия хронических заболеваний, В12-дефицитная, фолиеводефицитная), сложность диагностики и лечения
Слайд 63Железодефицитная анемия
Аденокарцинома толстого кишечника как причина железодефицитной анемии
Слайд 64Лабораторные признаки железодефицитной анемии
Низкий цветовой показатель (
в эритроцитах (< 30 пг/дл)
Гипохромия эритроцитов
Микроцитоз
Анизоцитоз
Пойкилоцитоз
Снижение сывороточного железа (
общей железосвязывающей способности сыворотки (>85 мкмоль/л)Снижение насыщения трансферрина железом
(< 10%)
Снижение ферритина сыворотки (<12 мкг/мл)
Снижение ферритина эритроцитов (< 5 пкг/кл)
Увеличение протопорфирина в эритроцитах
Слайд 66Железодефицитная анемия
Морфология костного мозга
Микронормобластический эритропоэз. Цитоплазма эритробластов скудная, вакуолизированная и
нерегулярная, отсутствие сидеробластов
Слайд 67Принципы лечения железодефицитной анемии
Устранение причины анемии
Заместительная терапия препаратами железа
- лечение
анемии
( 4-8 недель)
- насыщающая терапия
(3-6 месяцев)
- поддерживающая терапия
Слайд 68Необходимая суточная доза элементарного железа для лечения ЖДА в зависимости
от возраста
Новорожденные 3 мг/кг
Дети 1-3 лет 5-8 мг/кг
Дети 4-16 лет
100-120 мг/сутВзрослые 200-300 мг/сут
Слайд 69Препараты железа для лечения ЖДА
Железа сульфат + аскорбиновая кислота
Сорбифер Дурулес,
Egis, Венгрия. 1 таб. 320/100 мг
Гино-тардиферон, Pierre Fabre, Франция. 1
таб. 256/80 мгГемофер Пролангатум, Glaxo Smithkline, Великобритания, 1 др. 325/105 мг
Ферроплекс, Biogal,Венгрия. 1 таб. 50/10 мг
Железа глюконат
Апо-ферроглюконат, Apotec ink.,Канада, 1 таб. 300/33 мг
Слайд 70Препараты железа для лечения ЖДА (2)
Железа фумарат
Хеферол, Alcoloid, Македония, 1таб.
350/115 мг
Железа фумарат, Ремедика, 1 таб. 200/65 мг
Железа полиизомальтозат
Мальтофер, Акрихин,
Россия, 1 таб. 100 мг 1 амп=2 мл – 100 мг
Феррум Лек, Лек-Сандоз, 1 т. 100 мг
сироп 10мг/1 мл
Железа гидроксид сахарозный комплекс
Венофер, Vifor, Швейцария, амп. 5 мл,
1 мл – 20 мг (на 20 мл физ. Р-ра), в/в кап
Слайд 71Парентерально препараты железа могут применяться при следующих клинических ситуациях:
нарушение всасывания
при патологии кишечника (энтериты, резекция тонкого кишечника, синдром недостаточного всасывания),
обострение язвенной болезни желудка и 12перстной кишки и выраженные побочные эффекты при приеме внутрь препаратов железа,
дисфагия, нарушения глотания
проведение гемодиализа
Психические нарушения, отсутствие или нарушения сознания
Слайд 72Комплексные препараты железа для лечения ЖДА
Ферретаб (железа фумарат 154/50 мг
+ фолиевая кислота 500 мкг)
Биофер (полимальтозный комплекс железа
100/50 мг
+ фолиевая кислота 350 мкг) таб, сиропФерро-Фольгамма (сульфат железа 100/37 мг + фолиевая кислота 5 мг + цианкоболамин 10 мкг)
Фероглобин-В12
Актиферрин
Тотема
Витрум пренатал форте
Фарма-Мед Леди’с
Фенюльс
Слайд 73Оценка эффективности терапии ЖДА
Первые дни лечения – субъективное улучшение
7-10-й день
– увеличение ретикулоцитов в крови
3-4-я неделя – прирост гемоглобина и
числа эритроцитов4-8-я неделя – исчезновение гипохромии и микроцитоза, нормализация показателей красной крови
3-6 месяц – нормализация показателей качества жизни
Слайд 74В12-дефицитная анемия
Первое описание Combe and Andral в 1823 г.
Thomas Addison
- 1849 г.
Анемия Аддисона – Бирмера “злокачественная анемия”
Распространенность
0,1% населения
молодого возраста1% населения после 50 лет
4% населения после 75 лет
Слайд 75Основные этапы метаболизма витамина B12
Витамин В12 (кобаламин) – “внешний фактор”
99%
всасывается после связывания с внутренним фактором Кастла
1% всасывается без связи
с фактором КастлаВсасывание в подвздошной кишке 6-9 мкг/сутки, усвоение – около 4 мкг/сутки
В сыворотке кобаламин связывается с транскобаламином
Циркулирует в плазме крови 0,1% от общего количества в организме
Основное депо – печень, постоянная рециркуляция
(печень – кишечник – кровь – печень)
С мочой выводится ежедневно 2-5 мкг/сутки
Кобаламин в качестве кофакторов участвует в синтезе нуклеиновых кислот, в процессе синтеза и регенерации миелина, в обмене жирных кислот
Слайд 76Наиболее частые причины В12-дефицитных анемий
Дефицит пищевой
Недостаток или отсутствие внутреннего
фактора Кастла
1). Пернициозная анемия
а) врожденная форма
б) взрослая форма
2) Операции
на желудке Нарушение функции внутреннего фактора
Нарушение всасывания витамина В12
Биологическая конкуренция
Слайд 78Пернициозная анемия. Антитела к париетальным клеткам желудка (84% больных). Метод
непрямого иммунофлюоресцентного окрашивания
У 56% больных антитела к внутреннему фактору
Кастла в сыворотке крови и у 75% больных в желудочном соке
Частое сочетание с наличием аутоантител к щитовидной железе
Слайд 80Клинические проявления B12-дефицитной анемии
Симптомы анемии и поражения нервной системы (фуникулярный
миелоз)
Триада симптомов:
Слабость
Болезненный язык (глоссит)
Парастезии
Возможен гемолитический компонент анемии , спленомегалия, желтоватый
оттенок кожиСлайд 81Мегалобластная анемия
Глоссит –увеличенный малиновый
язык, лакированный язык, болезненный, чувствительный к
горячему и кислому
Ангулярный хеилит
Слайд 82Неврологические проявления при
В12-дефицитной анемии
Повышенные рефлексы, клонусы, патологические рефлексы Бабинского,
Россолимо, Бехтерева, Оппенгейма, опоясывающие боли, гипотония, расстройство функции тазовых органов.
Возможны психические нарушения.Выраженная слабость,
Спастические парезы и параличи,
Тяжелая
Уменьшенение вибрационной и позиционной чувствительности
Слабость,
Неустойчивая походка,
Неуклюжесть
Умеренная
Отсутствие или слабые проявления нарушения осязания и температурной чувствительности
Парастезии
Легкая
Физикальные признаки
Симптомы
Степень поражения нервной системы
Слайд 83Лабораторные признаки В12-дефицитной анемии
Макроцитарная анемия (средний объем эритроцитов >100 мкм3)
Увеличение
цветового показателя
Гиперхромия эритроцитов
Овалоцитоз
Анизоцитоз
Пойкилоцитоз
Кольца Кебота, тельца Жоли
Базофильная пунктация эритроцитов
Лейкопения
Нейтропения
Гиперсегментация ядер гранулоцитов,
гигантские гранулоцитыТромбоцитопения
Панцитопения
Мегалобластоидное кроветворение (синий костный мозг)
Снижение концентрации В12 в сыворотке крови
Антитела к внутреннему фактору Кастла, париетальным клеткам желудка
Увеличение метилмалоновой кислоты в моче
Проба Шилинга
Слайд 86Лечение В12-дефицитной анемии
Устранение причины (если возможно)
Цианкобаламин или гидроксикобаламин
100-200 мкг/сутки в/м
ежедневно 7 дней
затем при увеличении ретикулоцитов в крови в той
же дозе 3-4 раза в неделю в течение 2-х недель, затем 1 раз в неделю 4-6 недельПри выраженной неврологической симптоматике 500-1000 мкг/сутки в/м или в/в
Поддерживающая терапия – 200 мкг/сутки 5-7 дней 1 раз в год
При умеренной B12-дефицитной анемии (пищевой) возможен прием препаратов per os
300-1000 мкг/сутки
Слайд 87Причины фолиеводефицитной анемии
Пищевой дефицит
(суточная потребность 25-100 мкг у детей,
150-200 мкг у взрослых)
Повышенное потребление
1) алкоголизм и цирроз
2) беременность
3) младенческий
возраст4) заболевания, связанные с повышенной клеточной пролиферацией (злокачественные опухоли)
Лекарственно-индуцированный дефицит (контрацептивы, барбитураты, противосудорожные)
Обширная резекция кишечника
Конкурентное потребление
Врожденная малоабсорбция фолиевой кислоты
Слайд 88Клиническая симптоматика фолиеводефицитной анемии
Клинические проявления как при В12-дефицитной анемии кроме
неврологической симптоматики
(исключение – алкогольная полинейропатия)
Редко присутствует гемолитический компонент анемии и
спленомегалияСлайд 89Фолиеводефицитная анемия
Спонтанные кровоизлияния в кожу у больной 34 лет с
мегалобластной анемией, развившейся на фоне пищевого дефицита фолиевой кислоты и
алкоголизма.Hb 8 г/дл, ЦП 1,2
средний объем эритроцитов 115 мкм3,
тромбоциты 2,0 х 109/л